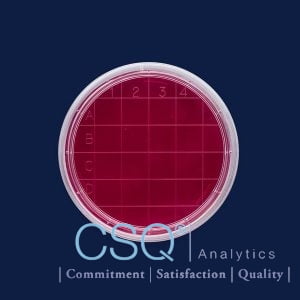

petri dish basket – stainless steel – 1 piece
- Manufactured from high quality, chemical and corrosion resistant AISI 304 grade stainless steel.
- Ideal tool for transportation and autoclaving of petri dishes.
Additional information
| Weight | 0.1412 kg |
|---|---|
| Dimensions | 21 × 45 × 11 cm |